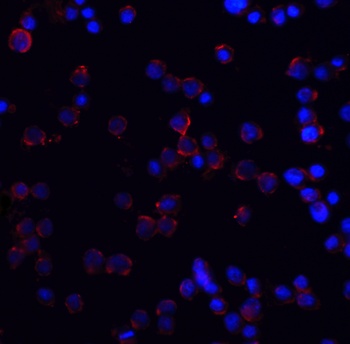
DR4 Antibody抗体，orb1239343，bior

相关产品推荐更多 >
万千商家帮你免费找货
0 人在求购买到急需产品
- 详细信息
- 技术资料
- 抗体名:
DR4 Antibody抗体
- 抗体英文名:
DR4 Antibody
- 靶点:
TNFRSF10A
- 浓度:
1 mg/ml
- 应用范围:
ELISA, ICC, IF, WB
- 适应物种:
Human, Mouse, Rat
- 保质期:
6-12个月
- 抗原来源:
详询
- 目录编号:
orb1239343
- 级别:
科研级
- 库存:
88
- 供应商:
biorbyt
- 标记物:
Unconjugated
- 克隆性:
Polyclonal
- 形态:
Liquid
- 亚型:
IgG
- 免疫原:
Anti-DR4 antibody (orb1239343) was raised against a peptide corresponding to 20 amino acids near the amino terminus of human DR4. The immunogen is located within the first 50 amino acids of DR4.
- 规格:
0.02 mg
产品描述:DR4 Antibody
别名:DR4 Antibody: DR4, APO2, CD261, TRAILR1, TRAILR-1, DR4, Tumor necrosis factor receptor superfamily member 10A, Death receptor 4, TRAIL receptor 1
免疫原:Anti-DR4 antibody (orb1239343) was raised against a peptide corresponding to 20 amino acids near the amino terminus of human DR4. The 免疫原 is located within the first 50 amino acids of DR4.
分子量:Predicted: 50kDObserved: 55kD (Post-modification: 1 N-linked glycosylation)
防腐剂:DR4 Antibody is supplied in PBS containing 0.02% sodium azide.
纯化:DR4 Antibody is affinity chromatography purified via peptide column.
保存说明:Maintain refrigerated at 2-8°C for up to 2 weeks. For long term storage store at -20°C in small aliquots to prevent freeze-thaw cycles.
NCBI:AAC51226
UniProt ID:O00220
Note:For research use only.










别名:DR4 Antibody: DR4, APO2, CD261, TRAILR1, TRAILR-1, DR4, Tumor necrosis factor receptor superfamily member 10A, Death receptor 4, TRAIL receptor 1
免疫原:Anti-DR4 antibody (orb1239343) was raised against a peptide corresponding to 20 amino acids near the amino terminus of human DR4. The 免疫原 is located within the first 50 amino acids of DR4.
分子量:Predicted: 50kDObserved: 55kD (Post-modification: 1 N-linked glycosylation)
防腐剂:DR4 Antibody is supplied in PBS containing 0.02% sodium azide.
纯化:DR4 Antibody is affinity chromatography purified via peptide column.
保存说明:Maintain refrigerated at 2-8°C for up to 2 weeks. For long term storage store at -20°C in small aliquots to prevent freeze-thaw cycles.
NCBI:AAC51226
UniProt ID:O00220
Note:For research use only.

KO Validation in HeLa Cells. Loading: 10 µg of HeLa WT cell lysates or DR4 KO cell lysates. Antibodies: DR4 orb1239343 (1 µg/mL) and beta-actin orb1240312 (1 µg/mL), 1 h incubation at RT in 5% NFDM/TBST. Secondary: Goat Anti-Rabbit IgG HRP conjugate at 1:10000 dilution.

Independent Antibody Validation (IAV) via Protein Expression Profile in Cell Lines. Loading: 15 µg of lysates per lane. Antibodies: DR4 orb1239340 (1 µg/mL), DR4 orb1239343 (4 µg/mL), beta-actin (1 µg/mL), and GAPDH (0.02 µg/mL), 1h incubation at RT in 5% NFDM/TBST. Secondary: Goat anti-rabbit IgG HRP conjugate at 1:10000 dilution.

Western Blot Validation in Cell Lines. Loading: 15 µg of cell lysates per lane. Antibodies: DR4 orb1239343 (4 µg/mL), 1h incubation at RT in 5% NFDM/TBST. Secondary: Goat anti-rabbit IgG HRP conjugate at 1:10000 dilution.
Immunofluorescence Validation of DR4 in HeLa Cells. Immunofluorescent analysis of 4% Fixative-fixed HeLa cells labeling DR4 with orb1239343 at 5 µg/mL, followed by goat anti-rabbit IgG secondary antibody at 1/500 dilution (red) and DAPI staining (blue). Image showing membrane staining on HeLa cells.

Immunocytochemistry Validation of DR4 in HeLa Cells. Immunocytochemical analysis of HeLa cells using anti-DR4 antibody (orb1239343) at 2 µg/ml. Cells was fixed with formaldehyde and blocked with 10% serum for 1 h at RT; antigen retrieval was by heat mediation with a citrate buffer (pH6). Samples were incubated with primary antibody overnight at 4°C. A goat anti-rabbit IgG H&L (HRP) at 1/250 was used as secondary. Counter stained with Hematoxylin.

KD Validation in SW480 Cells (Goda et al., 2008). The expression of DR4 was knocked down via DR4 siRNA, 24 h latercells were treated with dipyridamole for 24 h. DR4 protein expression detected by anti-DR4 antibodies was disrupted. Dipyridamole up-regulated the expression of DR4.

Immunofluorescence Validation of DR4 in Rat Brain (Cantarella et al., 2014). DR4 protein expression detected by anti-DR4 antibodies was increased after transient brain ischemia (tMCAO) and decreased after pre-conditioning stimulus. Confocal microscopic images displaying NeuN (a, d, g) (green), DR4 (b, e, h) (red), and Merge (c, f, i) (yellow) in the brain peri-ischemic region of rats after 5 h.

Immunocytochemistry Validation of DR4 in Human Melanoma Cells (Ekmekcioglu et al., 2008). MeWo melanoma cells were exposed to affinity-purified MDA7/IL-24. After 48 h of treatment, cells were collected and cytospins prepared for cytochemical assessment of their TRAIL receptor (R1 and R2) expression (anti-DR4 or anti-DR5, AEC, hematoxylin). Both DR4 and DR5 expression were upregulated in MeWo cells after treatment.

KD Validation in HeLa Cells (Horinaka et al., 2005). HeLa cells were transfected with DR4siRNA or LacZ control siRNA. At 24 h after transfection, the cells were treated with or without 20 µM luteolin for 24 h. Western blot analysis was carried out with anti-DR4 antibodies. DR4 expression was markedly reduced after DR4 knockdown.

Immunohistochemistry Validation of DR4 in Human Colon Tumors (Devetzi et al., 2016). DR4 expression in human colon tumors detected by anti-DR4 antibodies. Strong immunoreactivity is shown for DR4 in T167. Moderate immunoreactivity is shown for DR4 in T187.
风险提示:丁香通仅作为第三方平台,为商家信息发布提供平台空间。用户咨询产品时请注意保护个人信息及财产安全,合理判断,谨慎选购商品,商家和用户对交易行为负责。对于医疗器械类产品,请先查证核实企业经营资质和医疗器械产品注册证情况。
技术资料暂无技术资料 索取技术资料
DR4 Antibody抗体,orb1239343,biorbyt
¥3770










